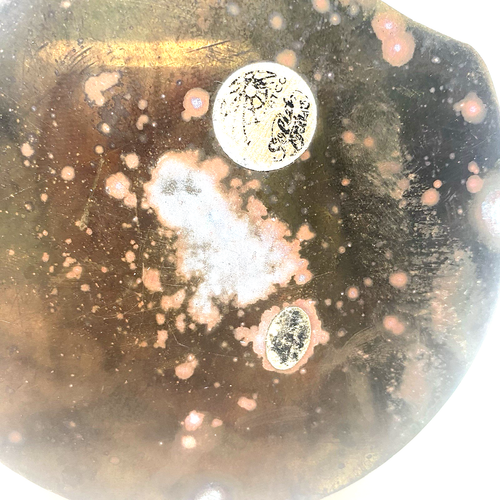
Lote De Colección 4 Anidación Latón Sea Shell Almeja Ostra Bisagra Baratija Caja de Alijo MCM AÑOS 70 - Imagen 13 de 22
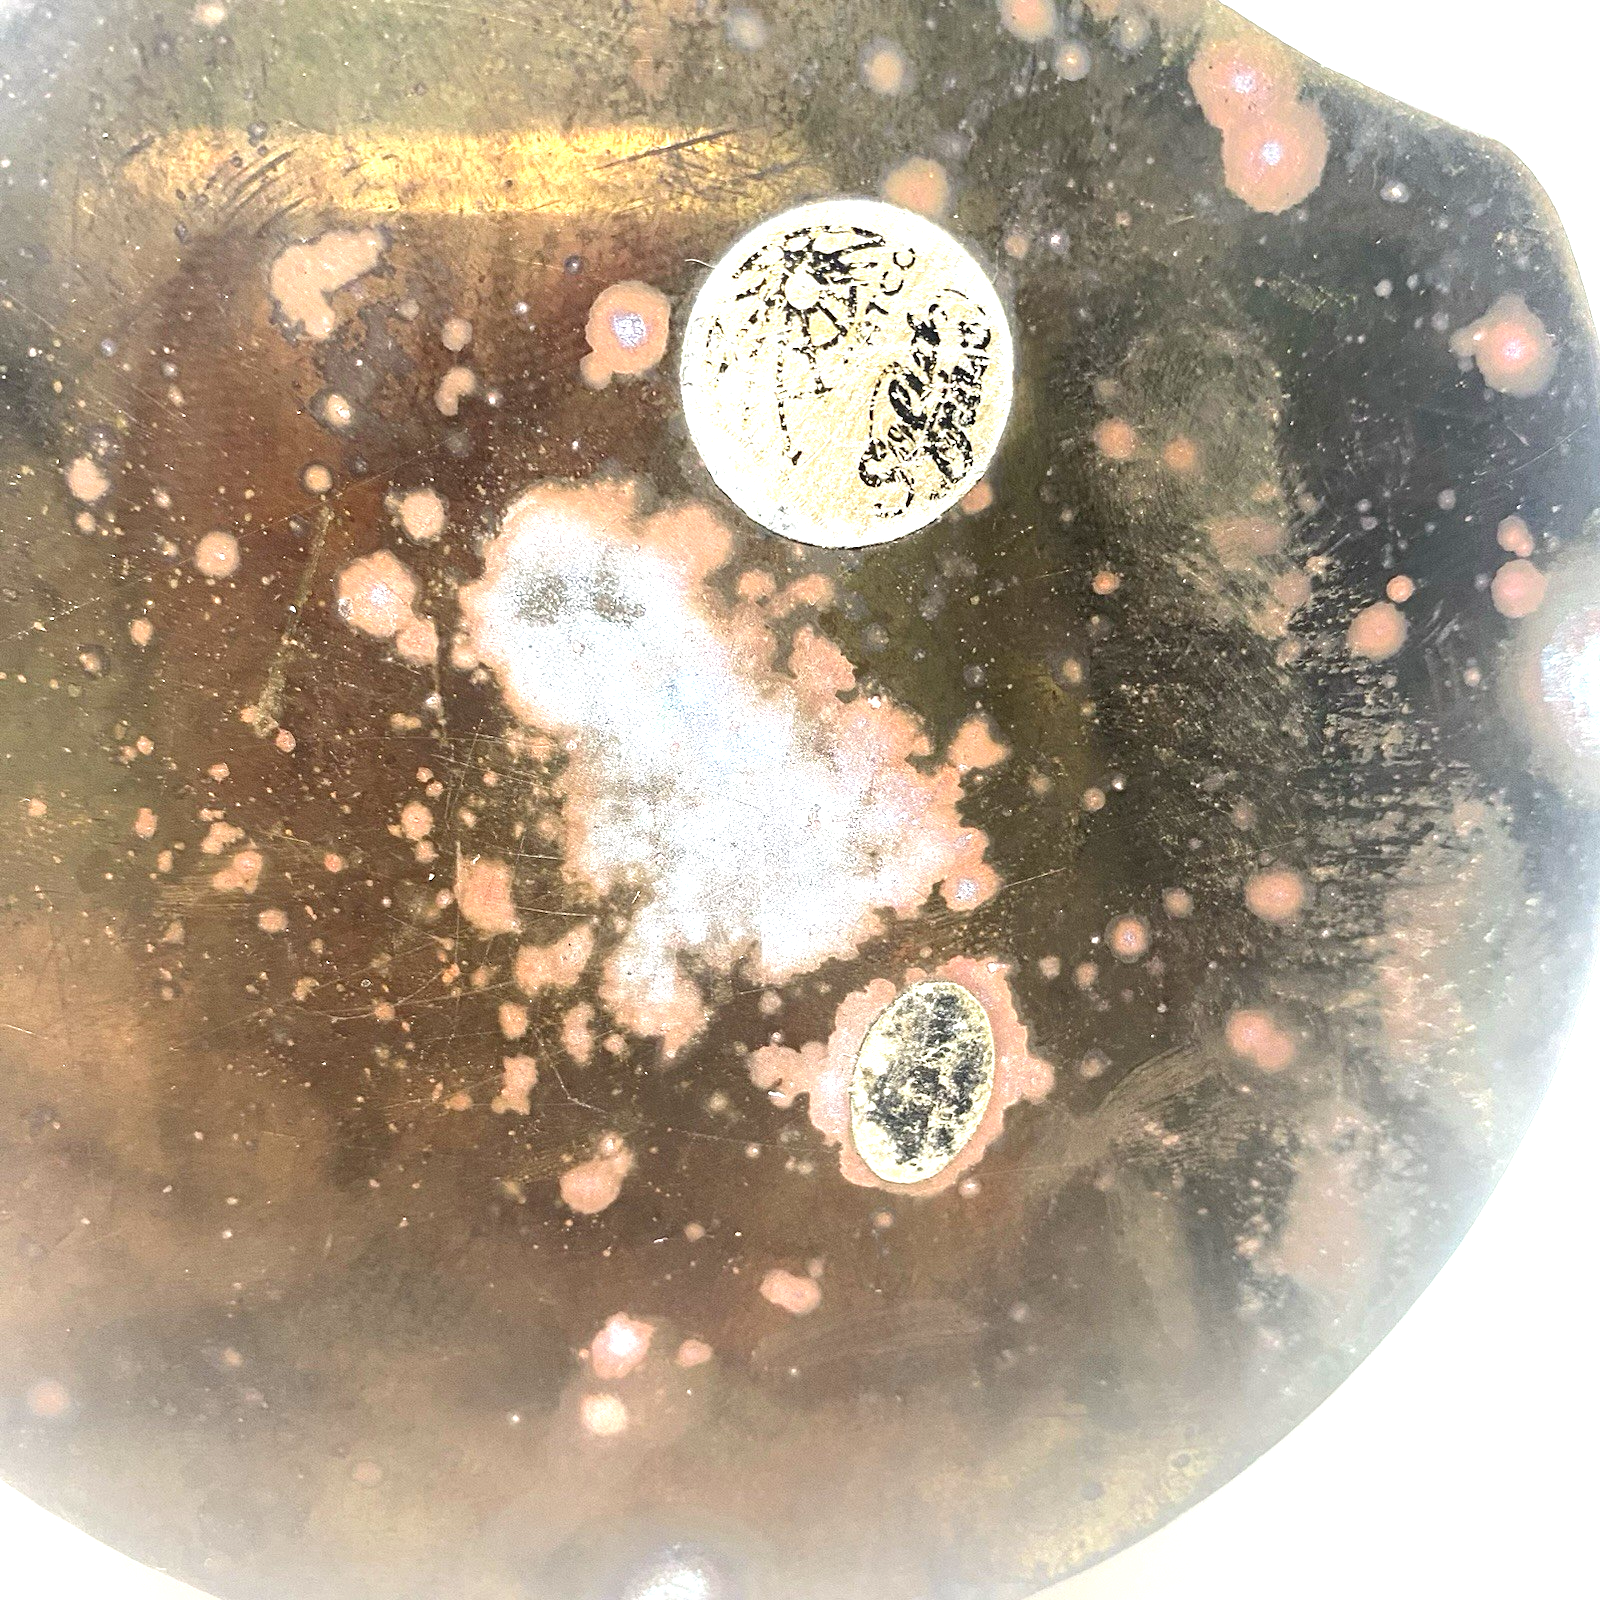
Imagen 13 de 22

Imagen 1 de 22

Galería
Imagen 1 de 22

¿Quieres vender uno?
Lote De Colección 4 Anidación Latón Sea Shell Almeja Ostra Bisagra Baratija Caja de Alijo MCM AÑOS 70-
USD99,95
Aproximadamente86,22 EUR
o Mejor oferta
Estado:
Oops! Looks like we're having trouble connecting to our server.
Refresh your browser window to try again.
Envío:
USD17,15 (aprox. 14,79 EUR) USPS Ground Advantage®.
Ubicado en: Daytona Beach, Florida, Estados Unidos
Entrega:
Entrega prevista entre el mié. 19 nov. y el sáb. 22 nov. a 94104
Devoluciones:
30 días para devoluciones. El comprador paga el envío de la devolución..
Pagos:
Compra con confianza
Sobre este artículo
El vendedor asume toda la responsabilidad de este anuncio.
N.º de artículo de eBay:127446779423
Características del artículo
- Estado
- Pattern
- Shells
- Shape
- clam
- Occasion
- All Occasions
- Color
- Gold
- Material
- Brass
- Subject
- Coastal
- Brand
- Shell
- Type
- Trinket Box
- Department
- Adults, Teens
- Era
- Late 20th Century (1970-1999)
- Customized
- No
- Number in Pack
- 4
- Packaging
- Box
- Original/Reproduction
- Original
- Style
- Bohemian
- Theme
- Nautical
- Collection
- Keepsake Boxes
- Features
- Boxed, With Lid
- Time Period Manufactured
- 1970-1979
- Finish
- Antique Brass
- Room
- Any Room
- Engraved
- No
- Handmade
- No
Descripción del artículo del vendedor
Acerca de este vendedor
smileythingsresale
100% de votos positivos•538 artículos vendidos
Registrado como vendedor particularPor tanto, no se aplican los derechos de los consumidores derivados de las leyes de protección de los consumidores de la UE. La Garantía al cliente de eBay sigue aplicando a la mayoría de compras. Más informaciónMás información
Votos de vendedor (214)
- d***b (201)- Votos emitidos por el comprador.Últimos 6 mesesCompra verificadaReceived the dishes in the mail. Unfortunately the post office must have thrown the box around as one of the dishes broke. I let the buyer know and he provided a partial refund for the one dish that was shattered after I sent over pictures. I greatly appreciate this buyer refunding me for the item that was shattered and hopefully he can dispute this with the post office. The bowls were wrapped in bubble wrap and were secure so I don’t know how the seller could have prevented this from happeningRespuesta de smileythings- Votos a los que ha respondido el vendedor smileythings.- Votos a los que ha respondido el vendedor smileythings.Thank you for your purchase and if you need other pieces in that pattern ask as I may have them.Set Of 3 - Corelle Wildflower Lime Green Rim Cereal Bowls 6 1/4" Spring Meadow (#126352254105)
- t***i (942)- Votos emitidos por el comprador.Últimos 6 mesesCompra verificadaJust as described with excellent packing and quick shipping. Great value for the buy. Thank you.Respuesta de smileythings- Votos a los que ha respondido el vendedor smileythings.- Votos a los que ha respondido el vendedor smileythings.Thank You
- b***o (47)- Votos emitidos por el comprador.Últimos 6 mesesCompra verificadaFast shipping and very well packed to ensure my vintage items didn't suffer any damage!! Very happy overall with description, ship fees, and packing. Great seller!Respuesta de smileythings- Votos a los que ha respondido el vendedor smileythings.- Votos a los que ha respondido el vendedor smileythings.Thank YouVintage Pyrex Black Milk Glass 8oz D-Handled Coffee Tea Mugs Cups Lot of 3 (#126352263763)
Más que explorar:
- Cromos sueltos de deportes de coleccionismo, fútbol, Temporada 1981, Años 70,
- Botones de colección de coleccionismo,
- Álbumes de pegatinas, packs de pegatinas y repetidas lotes y colecciones,
- Cromos sueltos de deportes de coleccionismo, fútbol, Temporada 1990 Años 90,
- Cromos sueltos de deportes de coleccionismo, fútbol, Temporada 1983 Años 80,
- Cromos sueltos de deportes de coleccionismo Panini, fútbol, la liga Años 90,
- Cromos sueltos de deportes de coleccionismo originales, fútbol, Años 80,
- Cromos sueltos de deportes de coleccionismo, fútbol, Temporada 1982, Años 80,
- Cromos sueltos de deportes de coleccionismo, fútbol, Temporada 1986 Años 80,
- Cromos sueltos de deportes de coleccionismo, fútbol, Temporada 2009 Años 80